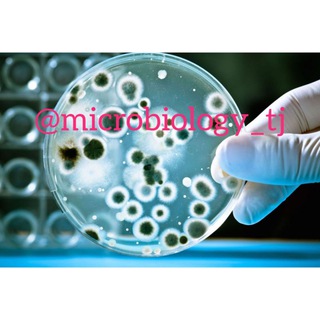

МАНЯ СЕКСКУРСОВОД Telegram канал
9
Маня, Искусство, Алкоголь.
Пишу буквами, говорю ртом.
Вот сюда можно писать в личку @maniarasstegaeva
Telegram канал "МАНЯ СЕКСКУРСОВОД" относится к категории "#Образование". Всего у канала "МАНЯ СЕКСКУРСОВОД" - 9 подписчиков. Закажите рекламу или свяжитесь с владельцем телеграм канала.
Похожие каналы

9543 подписчиков
Магазин для настоящих мужчин
Сделать заказ @KingBriton777
Доставка по всей России
Отзывы https://t.me/nozhi_podarki_otziv
Ссылка магазина для друзей
https://t.me/+D6-Jf7WFJallNTUy
Канал размещен в категории #Образование

9046 подписчиков
Факты | История | Наука |
Необычные факты каждый день.
Узнавай что-то новое вместе с нами.
Наши каналы @nezznal и @logika_rus
По рекламе: @ekspa_adv_bot
Менеджер (можно оплачивать): @ekspa_msk
Канал размещен в категории #Образование
Канал размещен в категории #Образование
Канал размещен в категории #Образование

4817 подписчиков
Познавательные мемы, широкий охват тем, уникальные идеи и оригинальное оформление. Наскучил однотипный контент? Тогда вы по адресу :)
Канал размещен в категории #Образование

744 подписчиков
Канал для неравнодушных жителей города Уфы.
Канал создан для получения обратной связи к эфирам "Аспекты городской среды" и проведения опросов.
Контакт для связи - @e_pann_duss
Канал размещен в категории #Образование

1440 подписчиков
Генеалогический и историко-краеведческий канал Проекта "Магометанская генеалогия"
Сохраним имена наших предков!
Канал размещен в категории #Образование

12398 подписчиков
Подпишитесь на канал «Пермэнергосбыт» и будете в курсе самых энергичных новостей Пермского края!
Канал размещен в категории #Образование

31379 подписчиков
О катастрофах и происшествиях в России и в мире, их причинах и значении для безопасности полётов.
Связь
@Safetyofficerr
Канал размещен в категории #Образование
Канал размещен в категории #Образование
Канал размещен в категории #Образование

5014 подписчиков
Warning: Many users reported this account as a scam or a fake account. Please be careful, especially if it asks you for money.
Канал размещен в категории #Образование
719 подписчиков
THE MOST SIMPLIFIED DATA AND MATERIALS ON MICROBIOLOGY AND IMMUNOLOGY WITH A CLINICAL BASIS
САМЫЕ УПРОЩЕННЫЕ ДАННЫЕ И МАТЕРИАЛЫ ПО МИКРОБИОЛОГИИ И ИММУНОЛОГИИ С КЛИНИЧЕСКИМ ОСНОВАНИЕМ
Видеолекции
mp...
Канал размещен в категории #Образование

429 подписчиков
Первый действующий канал посвященный колонизации Марса.
космос, cosmos, астрономия, Илон Маск
Связь @MishkaGummo по рекламе и доп скидкам сюда же)
Реклама: @toby_media
Канал размещен в категории #Образование

605 подписчиков
Адрес официального сайта ГБПОУ КК Крымский индустриально-строительный техникум http://spokist.ru/
Канал размещен в категории #Образование